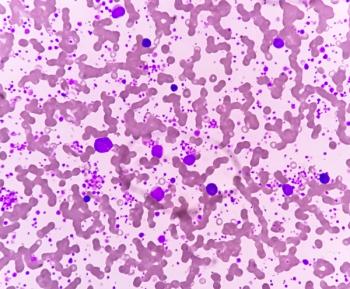
Chronic myeloid leukemia (CML) in accelerated phase with thrombocytosis. Chronic myelogenous leukemia. | Image Credit: © Saiful52 - stock.adobe.com

At the 2023 Gulf Coast Conference, LCGC spoke with John Wasson of Wasson-ECE Instrumentation, who discussed the process of retrieving high-quality, real-time data from chemical processing plant streams. This interview was one of four conducted live at GCC 2023.